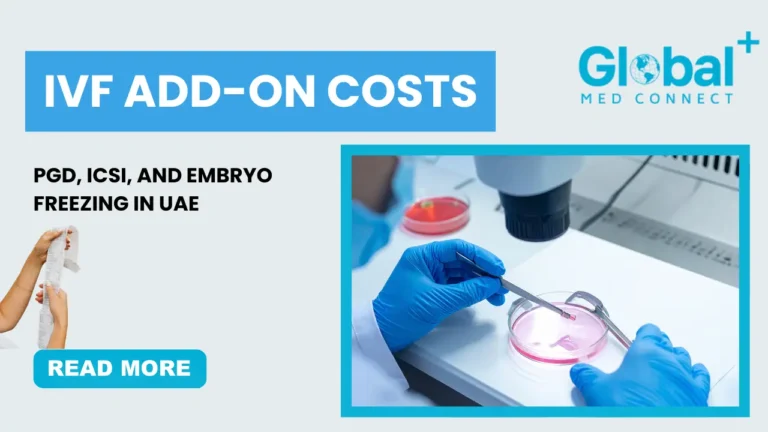
IVF add-on costs in UAE showing PGD, ICSI, and embryo freezing procedures with embryologist working in a lab at Global Med Connect.

Understanding IVF add-on costs is one of the most important steps for couples planning fertility treatment in the UAE. As more families choose advanced reproductive options such as PGD, ICSI, and embryo freezing, having transparent pricing and clarity can significantly reduce stress. This guide explains everything you need to know about the cost of these IVF add-ons, how they influence treatment success, and how to plan your fertility budget effectively.
What Are IVF Add-ons and Why Do Their Costs Matter?
IVF add-ons are optional or recommended procedures that support the main IVF cycle. They can improve fertilization rates, genetic safety, pregnancy chances, or long-term planning for future cycles. Because they impact clinical outcomes and financial planning, understanding IVF add-on costs helps couples make informed decisions aligned with medical needs and budget.
These add-ons are commonly suggested in the UAE for patients with previous IVF failures, male infertility challenges, advanced maternal age, or for those planning multiple future pregnancies.
Understanding the Cost of PGD, ICSI, and Embryo Freezing in UAE
Below is a breakdown of the most widely used IVF add-ons in the UAE and their expected pricing in 2026.
PGD/PGT-A Testing Costs in UAE
Preimplantation Genetic Diagnosis (PGD) or PGT-A is a specialized embryology procedure performed before embryo transfer. It screens embryos for chromosomal abnormalities to increase the chances of a healthy pregnancy.
Why PGD Matters
PGD is ideal for couples with:
Recurrent IVF failures
Known genetic disorders
Advanced maternal age (35+)
Recurrent miscarriages
Leading international health organisations such as the World Health Organization and the U.S. National Library of Medicine highlight how genetic screening may improve the likelihood of successful pregnancy for specific patient groups.
Typical PGD Costs in UAE
The cost varies depending on the number of embryos tested:
Screening for up to 4–6 embryos: AED 10,000 – AED 15,000
Additional embryos per test: AED 800 – AED 1,200 each
Full-panel PGT-A (comprehensive chromosome screening): AED 15,000 – AED 22,000
Factors influencing pricing:
Laboratory technology
Number of embryos
Whether multi-gene or single-gene disorders are included
For couples reviewing complete IVF expenses in UAE, it helps to also explore the full IVF cost overview in UAE through a detailed guide such as the comprehensive cost breakdown provided on Global Med Connect via their resource on IVF treatment expenses in UAE.
ICSI Costs in UAE
Intracytoplasmic Sperm Injection (ICSI) is among the most commonly added procedures in IVF cycles in the UAE.
Why ICSI Is Recommended
ICSI is ideal for:
Male infertility
Low sperm motility
Previous fertilisation failure
Unexplained infertility
According to the Mayo Clinic, ICSI significantly enhances the chances of fertilization, especially when sperm parameters are suboptimal.
Typical ICSI Costs in UAE
The price typically ranges between:
AED 2,500 – AED 5,000 per cycle
Factors that impact ICSI cost:
Fertility centre expertise
Embryology lab quality
Number of eggs requiring micro-injection
If you’re evaluating ICSI as part of your treatment, consider comparing it with information from repeat IVF cycle cost guides such as the detailed analysis available through Global Med Connect’s article on IVF repeat cycle expenses in UAE.
Embryo Freezing Costs in UAE
Embryo freezing (cryopreservation) is an essential service for couples planning multiple future cycles or wishing to preserve remaining embryos.
Benefits of Embryo Freezing
Cost-efficient for future cycles
Reduces ovarian stimulation requirements
Supports medical preservation before chemotherapy
Higher cumulative pregnancy success rates
Typical Embryo Freezing Costs in UAE
Most clinics follow a modular pricing model:
Freezing procedure for all viable embryos: AED 2,000 – AED 4,000
Annual storage fee: AED 1,000 – AED 2,500
Additional charges may include:
Thawing (AED 1,000 – AED 2,000)
FET (Frozen Embryo Transfer) cycle (AED 5,000 – AED 10,000)
For those considering multiple services, reading about fertility services for IVF will help understand when freezing and thawing align with overall treatment goals.
How IVF Add-on Costs Influence the Total IVF Budget
Since add-ons are targeted and specialiszed, they can increase the total cost of an IVF cycle. However, they often reduce the emotional and financial burden of repeated cycles by improving success rates.
Factors Affecting Overall Add-on Costs
Age of the patient
Number of embryos created
Genetic screening requirements
Type of infertility challenge
Clinic expertise and lab quality
A clear discussion with your fertility specialist is essential. The aim should be medical necessity rather than choosing every add-on available.
Are IVF Add-ons Worth the Cost?
Many couples wonder whether these add-ons justify the investment. For specific patient groups, such as those with male infertility (ICSI), genetic disorders (PGD), or long-term pregnancy planning (embryo freezing), these interventions can significantly improve outcomes.
However, every case is unique. Clinics in the UAE often personalise protocols to balance cost and success potential.
If you’re planning to evaluate your complete treatment expenses, you may refer to trusted resources like the expert-backed insights on the full IVF cost structure in the UAE, which offer clarity on primary and add-on component pricing.
Final Thoughts on IVF Add-on Costs in UAE
Navigating IVF add-on costs in the UAE becomes easier when you understand why each service is recommended, how it works, and what it adds to your overall treatment value. PGD, ICSI, and embryo freezing each play a specific role in enhancing success potential during IVF. While these add-ons require additional investment, they often contribute to fewer repeated cycles, better genetic outcomes, and increased peace of mind.
If you’re seeking expert support for IVF add-ons, fertility counselling, and complete IVF planning in the UAE, you can explore trusted guidance through Global Med Connect.
For expert care and advanced fertility solutions in UAE, visit Global Med Connect.
FAQs About IVF Add-on Costs in UAE
In the UAE, IVF add-on costs typically range from AED 2,500 to AED 22,000 depending on the procedure. ICSI usually costs AED 2,500–5,000, PGD/PGT-A ranges from AED 10,000–22,000, and embryo freezing costs AED 2,000–4,000 plus AED 1,000–2,500 annual storage fees. Prices vary by clinic, lab technology, and the number of embryos tested or stored.
No. IVF add-ons are recommended based on medical need, not as mandatory procedures. PGD is usually suggested for genetic risks or recurrent miscarriages, while ICSI is ideal for male infertility or prior fertilization issues. Your doctor evaluates whether these add-ons will improve success and justify the IVF add-on costs.
PGD (or PGT-A) may improve success rates for certain patients by identifying chromosomally normal embryos. Couples with recurrent failure, maternal age 35+, or known genetic conditions often benefit the most. Although the procedure adds to IVF add-on costs, it can reduce the need for repeated cycles.
Embryo freezing usually costs AED 2,000–4,000 for the procedure. Annual storage fees range from AED 1,000–2,500 depending on the facility. Additional costs include thawing fees and the Frozen Embryo Transfer (FET) cycle, which may cost AED 5,000–10,000.
Most insurance plans in the UAE do not cover IVF or related add-ons such as PGD, ICSI, or embryo freezing. A few premium policies may offer partial coverage, but it is uncommon. Patients should confirm with their insurer and discuss alternative payment plans or packages offered by clinics to manage IVF add-on costs.
Contact us
Have Questions? We're Just a Click Away!
Call us to this number for immediate support
+971 56 757 0688
+44 7570569435




